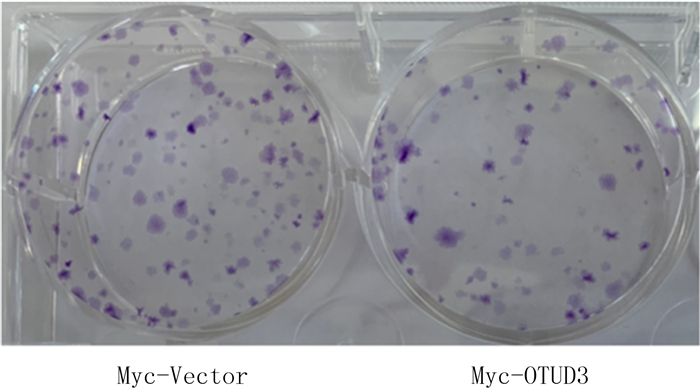
点击查看原图

胶质瘤是一种极为常见的原发性恶性颅内肿瘤,占中枢神经系统恶性肿瘤的81%[1]。目前胶质瘤的治疗方法包括手术、化疗和放疗等,但病人的中位生存期较短,预后差[2]。因此,研究胶质瘤发生发展机制对开发新的疗法有重要意义。泛素-蛋白酶体系统(UPS)是调节蛋白质最重要的体系,它通过在底物的泛素化和去泛素化之间建立动态平衡参与广泛的细胞过程的调节,如细胞周期、DNA损伤修复、凋亡、表观遗传和信号转导等[3-6]。近年来研究发现,泛素化酶和去泛素化酶参与肿瘤的发生发展,并可能成为潜在的抗癌靶点。泛素特异性蛋白酶USP39通过诱导mRNA成熟,增加含有WW结构域的转录调节子1(TAZ)的蛋白水平促进胶质瘤的发展进程[7-8]; 而敲除去泛素化酶USP8可间接靶向RNA结合蛋白SF2/ASF1,促进胶质瘤细胞的凋亡,从而应对胶质瘤复发[9]。OTUD3属于卵巢肿瘤蛋白酶(OTU)家族,也是一种去泛素化酶[10]。已有研究表明,OTUD3可能在细胞环境中参与促进或抑制肿瘤的发生[11-12]。本实验室的前期研究结果表明,与原代星形胶质细胞相比,大鼠C6星形胶质瘤细胞中的OTUD3蛋白表达显著降低[13]。为了研究OTUD3对星形胶质瘤发生的作用,本实验通过质粒转染高表达OTUD3,探究过表达OUTD3对C6星形胶质瘤细胞增殖的影响。现将结果报告如下。
1 材料与方法 1.1 实验材料本实验所用的细胞为大鼠C6星形胶质瘤细胞系,为贴壁生长的细胞。高糖DMEM细胞培养液(以色列BI公司),胎牛血清(FBS,北京全式金生物公司),青链霉素合剂、Cell Counting Kit-8(CCK-8)试剂盒(北京索莱宝公司)。
1.2 实验方法 1.2.1 细胞培养C6胶质瘤细胞接种于含体积分数0.10 FBS和体积分数0.01青链霉素合剂的高糖DMEM培养液,置于37 ℃、含体积分数0.05 CO2的培养箱中培养,待细胞密度达80%~90%时,用胰酶消化3 min,加入少量完全培养液终止消化,收集至50 mL离心管中,以1 000 r/min离心5 min,弃上清液后加入新鲜培养液,用吸管轻吹充分悬浮细胞,移至新的培养瓶中传代。
1.2.2 细胞转染将C6胶质瘤细胞悬液按照每孔1×105个细胞的密度接种于6孔板中,24 h后,待细胞密度达70%~80%时进行转染。实验分为Myc-Vector组和Myc-OTUD3组,分别转染Myc-Vector质粒载体和Myc-OTUD3质粒载体。向Myc-Vector组的基础培养液中加入Myc-Vector质粒,Myc-OTUD3组基础培养液中加入Myc-OTUD3质粒,静置5 min后与配制好的LipofectaminTM 2000混合液混合,室温静置10~20 min。向6孔板中每孔加入1 200 μL基础培养液及300 μL质粒混合液,置于含体积分数0.05 CO2的培养箱中培养,培养4~8 h后换新培养液继续培养至48 h。
1.2.3 Western Blot检测OTUD3蛋白表达将转染后的C6胶质瘤细胞6孔板取出,弃上清液,每孔加入100 μL细胞裂解液冰上裂解,提取细胞蛋白。每孔上样蛋白量为20 μg,以90 V恒定电压电泳,300 mA恒定电流转膜1 h,100 g/L脱脂奶粉室温封闭1.5 h。加一抗4 ℃过夜孵育,以TBST溶液清洗3次,每次10 min; 加二抗室温孵育1 h,以TBST溶液漂洗。配制ECL化学发光液进行显影。
1.2.4 CCK-8检测细胞增殖将转染48 h的C6胶质瘤细胞悬液按每孔100 μL接种于5个96孔板,每孔细胞数目为(3~4)×103个。每日同一时间点向96孔板中加入CCK-8溶液10 μL,置培养箱中避光培养1 h,用酶标仪(美国BioTek公司)检测波长450 nm处的吸光度,连续记录5 d,绘制细胞生长曲线。
1.2.5 细胞克隆形成实验用胰酶消化细胞后,将C6胶质瘤细胞悬液接种于6孔板中,置于37 ℃细胞培养箱中培养,2周后弃培养液,用预冷的PBS溶液缓慢冲洗,甲醇固定10 min,结晶紫染色10 min,观察结晶紫染色情况,统计着色的细胞集落数目。
1.3 统计学方法应用SPSS 22软件进行统计学分析,计量资料以x±s表示,两组间比较采用t检验,两因素设计资料比较采用析因设计的方差分析。P<0.05认为差异具有统计学意义。
2 结果 2.1 Myc-OTUD3质粒转染后细胞内OTUD3蛋白表达水平的变化Western Blot检测结果显示,与Myc-Vector组(0.403±0.065)相比较,Myc-OTUD3组(0.832±0.105)C6胶质瘤细胞中OTUD3蛋白表达水平明显升高(n=6,t=3.472,P<0.01)。见图 1。
![]() |
| 图 1 Western Blot检测质粒转染后细胞内OTUD3蛋白表达的变化 |
细胞转染Myc-OTUD3质粒后,连续5 d检测450 nm波长处的吸光度,析因设计的方差分析结果显示,转染和时间存在交互效应(F=12.300,P<0.001)。进行单独效应分析结果显示,与Myc-Vector组相比,Myc-OTUD3组在转染4、5 d时的细胞增殖水平降低,差异具有统计学意义(n=6,F=17.326、70.345,P<0.001),表明细胞生长明显受到抑制。见图 2。
![]() |
| 与Myc-Vector组相比,***F=17.326、70.345,P<0.001。 图 2 过表达OTUD3对C6胶质瘤细胞增殖的影响 |
细胞克隆形成实验结晶紫染色的结果显示,与Myc-Vector组(103.300±5.239)相比较,Myc-OTUD3组(77.670±4.702)的细胞克隆数显著降低(n=3,t=3.646,P<0.05)。见图 3。
![]() |
| 图 3 过表达OTUD3对C6胶质瘤细胞克隆形成能力的影响 |
神经胶质瘤是最具侵袭性的恶性脑肿瘤,具有较高的发病率和致死率。胶质母细胞瘤是最常见的胶质瘤组织学类型,约占胶质瘤的45%[14-15]。虽然基础研究和临床试验已进行多年,但胶质母细胞瘤仍是成年人最致命的原发性恶性脑肿瘤之一[16-17]。目前胶质母细胞瘤的标准化治疗是在可行的范围内进行手术切除,然后进行单独放疗或化疗与替莫唑胺药物联合治疗,但预后较差[18-19]。由于肿瘤组织学相同的病人预后不同,因此研究胶质瘤中不同的分子表达变化可能是开发新的有效治疗方法和提高病人生存率的有效途径。
人类基因组中总共编码90种去泛素化酶[20],OTU作为去泛素化酶的一个亚型,通过调节基因转录、细胞周期、免疫反应、炎症和肿瘤生长等,在多种生物调节过程中发挥重要作用[21-24]。含有OTU结构域的蛋白质(OTUD)是OTU的一个亚家族,OTUD3是OTU家族中的一种重要酶,由398个氨基酸组成[25]。近期的研究显示,OTUD3在癌症中发挥重要的作用,其表达下调与乳癌病人的不良预后相关,OTUD3作为一种肿瘤抑制因子通过直接去泛素化并稳定P53,促进肿瘤细胞对化疗药物的敏感性[26-27]。有研究表明,OTUD3作为肿瘤突变抑制因子人第10号染色体缺失并与张力蛋白同源的磷酸酶(PTEN,即MMAC1)的去泛素化酶,在乳癌OTUD3-PTEN轴中发挥去泛素化功能并稳定PTEN,在肿瘤抑制过程中起到重要作用[11, 28]。泛素特异性肽酶USP13能够促进卵巢癌的发展和转移[29]。此外,在肝细胞癌中OTUD3能够通过去泛素化增强α-辅肌动蛋白4(ACTN4)的稳定性,促进肝细胞癌的生长和转移[30]。尽管多项研究结果已经证明OTUD3参与癌症的进程[31-35],但目前关于OTUD3在胶质瘤特别是胶质母细胞瘤中发挥的细胞功能却少有研究。
本研究团队的前期研究结果已经证明,与正常脑组织相比,神经胶质瘤细胞中OTUD3的转录显著下调,而C6胶质瘤细胞中OTUD3的mRNA以及蛋白表达水平明显低于正常原代星形胶质细胞,且OTUD3高表达的胶质瘤病人比低表达的胶质瘤病人存活时间更长[13]。本次研究通过CCK-8和细胞克隆形成实验检测细胞增殖能力,结果表明,质粒转染高表达OTUD3可以降低C6星形胶质瘤细胞增殖水平,进一步说明了OTUD3对胶质瘤发生的作用,为靶向治疗胶质瘤提供了实验证据。
| [1] |
OSTROM Q T, PATIL N, CIOFFI G, et al. CBTRUS statistical report: primary brain and other central nervous system tumors diagnosed in the United States in 2013—2017[J]. Neuro-oncology, 2020, 22(12 Suppl 2): iv1-iv96. |
| [2] |
SOZIO P, FIORITO J, DI GIACOMO V, et al. Haloperidol metabolite Ⅱ prodrug: asymmetric synthesis and biological evaluation on rat C6 glioma cells[J]. European Journal of Medicinal Chemistry, 2015, 90: 1-9. DOI:10.1016/j.ejmech.2014.11.012 |
| [3] |
XIANG T X, LI L L, YIN X D, et al. The ubiquitin peptidase UCHL1 induces G0/G1 cell cycle arrest and apoptosis through stabilizing p53 and is frequently silenced in breast cancer[J]. PLoS One, 2012, 7(1): e29783. DOI:10.1371/journal.pone.0029783 |
| [4] |
NAGAMACHI A, NAKATA Y, UEDA T, et al. Acquired deficiency of A20 results in rapid apoptosis, systemic inflammation, and abnormal hematopoietic stem cell function[J]. PLoS One, 2014, 9(1): e87425. DOI:10.1371/journal.pone.0087425 |
| [5] |
JIN W L, MAO X Y, QIU G Z. Targeting deubiquitinating enzymes in glioblastoma multiforme: expectations and challenges[J]. Medicinal Research Reviews, 2017, 37(3): 627-661. DOI:10.1002/med.21421 |
| [6] |
LANCINI C, VAN DEN BERK P C, VISSERS J H, et al. Tight regulation of ubiquitin-mediated DNA damage response by USP3 preserves the functional integrity of hematopoietic stem cells[J]. The Journal of Experimental Medicine, 2014, 211(9): 1759-1777. DOI:10.1084/jem.20131436 |
| [7] |
CORDENONSI M, ZANCONATO F, AZZOLIN L, et al. The Hippo transducer TAZ confers cancer stem cell-related traits on breast cancer cells[J]. Cell, 2011, 147(4): 759-772. DOI:10.1016/j.cell.2011.09.048 |
| [8] |
DING K K, JI J X, ZHANG X, et al. RNA splicing factor USP39 promotes glioma progression by inducing TAZ mRNA maturation[J]. Oncogene, 2019, 38(37): 6414-6428. DOI:10.1038/s41388-019-0888-1 |
| [9] |
VASHISTHA V, BHARDWAJ S, YADAV B K, et al. Depleting deubiquitinating enzymes promotes apoptosis in glioma cell line via RNA binding proteins SF2/ASF1[J]. Biochemistry and Biophysics Reports, 2020, 24: 100846. DOI:10.1016/j.bbrep.2020.100846 |
| [10] |
MEVISSEN T E, HOSPENTHAL M K, GEURINK P P, et al. OTU deubiquitinases reveal mechanisms of linkage specifi-city and enable ubiquitin chain restriction analysis[J]. Cell, 2013, 154(1): 169-184. DOI:10.1016/j.cell.2013.05.046 |
| [11] |
YUAN L, LV Y R, LI H C, et al. Deubiquitylase OTUD3 regulates PTEN stability and suppresses tumorigenesis[J]. Nature Cell Biology, 2015, 17(9): 1169-1181. DOI:10.1038/ncb3218 |
| [12] |
DU T D, LI H C, FAN Y S, et al. The deubiquitylase OTUD3 stabilizes GRP78 and promotes lung tumorigenesis[J]. Nature Communications, 2019, 10(1): 2914. DOI:10.1038/s41467-019-10824-7 |
| [13] |
LIU Y Z, DU X X, ZHAO Q Q, et al. The expression change of OTUD3-PTEN signaling axis in glioma cells[J]. Annals of Translational Medicine, 2020, 8(7): 490. DOI:10.21037/atm.2020.03.51 |
| [14] |
LUDWIG K, KORNBLUM H I. Molecular markers in glioma[J]. Journal of Neuro-Oncology, 2017, 134(3): 505-512. DOI:10.1007/s11060-017-2379-y |
| [15] |
OSTROM Q T, BAUCHET L, DAVIS F G, et al. The epidemiology of glioma in adults: a "state of the science" review[J]. Neuro-oncology, 2014, 16(7): 896-913. DOI:10.1093/neuonc/nou087 |
| [16] |
CHEN R, COHEN A L, COLMAN H. Targeted therapeutics in patients with high-grade gliomas: past, present, and future[J]. Current Treatment Options in Oncology, 2016, 17(8): 42. DOI:10.1007/s11864-016-0418-0 |
| [17] |
BUCKNER J C. Factors influencing survival in high-grade gliomas[J]. Seminars in Oncology, 2003, 30: 10-14. DOI:10.1016/S0093-7754(03)00120-9 |
| [18] |
STUPP R, MASON W P, VAN DEN BENT M J, et al. Radiotherapy plus concomitant and adjuvant temozolomide for glioblastoma[J]. The New England Journal of Medicine, 2005, 352(10): 987-996. DOI:10.1056/NEJMoa043330 |
| [19] |
YUNG W K, ALBRIGHT R E, OLSON J, et al. A phase Ⅱ study of temozolomide vs. procarbazine in patients with glioblastoma multiforme at first relapse[J]. British Journal of Cancer, 2000, 83(5): 588-593. DOI:10.1054/bjoc.2000.1316 |
| [20] |
COYNE E S, WING S S. The business of deubiquitination-location, location, location[J]. F1000 Research, 2016, 5: 163. DOI:10.12688/f1000research.7220.1 |
| [21] |
DENG J J, HOU G X, FANG Z X, et al. Distinct expression and prognostic value of OTU domain-containing proteins in non-small-cell lung cancer[J]. Oncology Letters, 2019, 18(5): 5417-5427. |
| [22] |
YANG J M. Emerging roles of deubiquitinating enzymes in human cancer[J]. Acta Pharmacologica Sinica, 2007, 28(9): 1325-1330. DOI:10.1111/j.1745-7254.2007.00687.x |
| [23] |
PRIOLO C, TANG D, BRAHAMANDAN M, et al. The isopeptidase USP2a protects human prostate cancer from apoptosis[J]. Cancer Research, 2006, 66(17): 8625-8632. DOI:10.1158/0008-5472.CAN-06-1374 |
| [24] |
ZHAO Q Q, LI Y X, DU X X, et al. Effects of deubiquitylases on the biological behaviors of neural stem cells[J]. Deve-lopmental Neurobiology, 2021, 81(6): 847-858. DOI:10.1002/dneu.22844 |
| [25] |
GARSHOTT D M, SUNDARAMOORTHY E, LEONARD M, et al. Distinct regulatory ribosomal ubiquitylation events are reversible and hierarchically organized[J]. eLife, 2020, 9: e54023. DOI:10.7554/eLife.54023 |
| [26] |
PU Q, LV Y R, DONG K, et al. Tumor suppressor OTUD3 induces growth inhibition and apoptosis by directly deubiquitinating and stabilizing p53 in invasive breast carcinoma cells[J]. BMC Cancer, 2020, 20(1): 583. DOI:10.1186/s12885-020-07069-9 |
| [27] |
XIAO Z N, ZHANG P J, MA L. The role of deubiquitinases in breast cancer[J]. Cancer Metastasis Reviews, 2016, 35(4): 589-600. DOI:10.1007/s10555-016-9640-2 |
| [28] |
ZHANG J S, ZHANG P J, WEI Y K, et al. Deubiquitylation and stabilization of PTEN by USP13[J]. Nature Cell Biology, 2013, 15(12): 1486-1494. DOI:10.1038/ncb2874 |
| [29] |
KWON J, CHOI H, WARE A D, et al. USP13 promotes development and metastasis of high-grade serous ovarian carcinoma in a novel mouse model[J]. Oncogene, 2022. DOI:10.1038/s41388-022-02224-x |
| [30] |
XIE P Y, CHEN Y L, ZHANG H F, et al. The deubiquitinase OTUD3 stabilizes ACTN4 to drive growth and metastasis of hepatocellular carcinoma[J]. Aging, 2021, 13(15): 19317-19338. DOI:10.18632/aging.203293 |
| [31] |
ZHANG P F, LI C N, LI H C, et al. Ubiquitin ligase CHIP regulates OTUD3 stability and suppresses tumour metastasis in lung cancer[J]. Cell Death and Differentiation, 2020, 27(11): 3177-3195. DOI:10.1038/s41418-020-0571-7 |
| [32] |
WANG M, LI Y, XIAO Y Y, et al. Nicotine-mediated OTUD3 downregulation inhibits VEGF-C mRNA decay to promote lymphatic metastasis of human esophageal cancer[J]. Nature Communications, 2021, 12(1): 7006. DOI:10.1038/s41467-021-27348-8 |
| [33] |
GENG W W, SONG H Y, ZHAO Q Q, et al. miR-520h sti-mulates drug resistance to paclitaxel by targeting the OTUD3-PTEN axis in breast cancer[J]. BioMed Research Internatio-nal, 2020, 2020: 9512793. |
| [34] |
QI L Y, YAO Y, ZHANG T T, et al. A four-mRNA model to improve the prediction of breast cancer prognosis[J]. Gene, 2019, 721: 144100. DOI:10.1016/j.gene.2019.144100 |
| [35] |
HONG W, LI A, LIU Y H, et al. Clonal hematopoiesis mutations in patients with lung cancer are associated with lung cancer risk factors[J]. Cancer Research, 2022, 82(2): 199-209. DOI:10.1158/0008-5472.CAN-21-1903 |
2022, Vol. 58